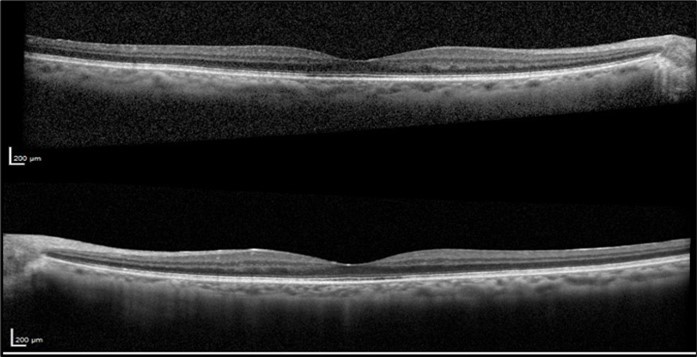
Optical coherence tomography of both eyes revealing the sustained resolution of the cystoid macular edema after Leflunomide discontinuation.

Leflunomide-Induced Cystoid Macular Edema: A Rare Case Report
Abstract
Introduction
Cystoid macular edema (CME) is a sight-threatening condition caused by fluid accumulation in the macula due to blood-retinal barrier disruption. Various factors, including drug reactions, can lead to retinal fluid leakage. Leflunomide, a disease-modifying anti-rheumatic drug, marked significant progress in managing rheumatoid arthritis. Although effective, Leflunomide has rarely been linked to CME. This report presents a unique case of Leflunomide-induced CME, adding to the limited literature on this subject.
Methods
We report the case of a 75-year-old female with rheumatoid arthritis treated with Leflunomide, presenting with bilateral CME and reduced visual acuity (VA). Comprehensive ophthalmic evaluations, including VA tests, fundus examination, and optical coherence tomography, were conducted.
Results
The patient presented with CME and decreased VA in both eyes for several months. She had undergone cataract surgery 20 years prior and was using topical nepafenac, dorzolamide, and dexamethasone. Initial VA was OD 20/50 and OS 20/40. VA improved with treatment, but CME recurred upon discontinuation. The patient had been on Leflunomide for one year. After consulting with the Rheumatology department and considering a previous case of bilateral Leflunomide-induced CME, the drug was discontinued. CME resolved without recurrence or the need for topical treatment. At her final visit, VA was OU 20/25.
Conclusion
This case highlights Leflunomide as a potential, though rare, cause of CME. It emphasizes considering systemic medications in CME diagnosis. Timely discontinuation of Leflunomide may resolve CME and prevent further visual impairment. Further studies are needed to understand this rare side effect comprehensively.
Author Contributions
Academic Editor: Asaad Ghanem, Mansoura ophthalmic center, mansoura university, mansouraam
Checked for plagiarism: Yes
Review by: Single-blind
Copyright © 2024 João Alves Ambrósio, et al
This is an open-access article distributed under the terms of the Creative Commons Attribution License, which permits unrestricted use, distribution, and reproduction in any medium, provided the original author and source are credited.
Competing interests
The authors declare no conflict of interest.
Citation:
Introduction
The American Academy of Ophthalmology defines Cystoid Macular Edema (CME) as the retinal thickening of the macula caused by a disruption of the blood-retinal barrier. This disruption leads to leakage from the perifoveal retinal capillaries and fluid accumulation within the intracellular spaces of the retina, primarily in the outer plexiform layer. 1, 2 Visual loss occurs due to retinal thickening and fluid collection that distorts the architecture of the photoreceptors. The etiology of CME is multifaceted, encompassing various systemic and local factors, including ocular surgeries, inflammatory diseases, and adverse drug reactions. A variety of these risk factors can disrupt the delicate balance within the retinal environment, which involves the osmotic force, hydrostatic force, capillary permeability, and tissue compliance within the vasculature. Among the drugs known to cause CME, Leflunomide has been identified as a rare contributor. 3 Leflunomide, an immunomodulatory drug, was the first oral agent labeled for managing active rheumatoid arthritis by slowing disease progression, reducing joint damage, and alleviating symptoms. This represented a significant advancement in rheumatoid arthritis treatment. 4 To the best of our knowledge, just one case report exists in the literature documenting Leflunomide-induced bilateral CME.
Methods
This case report focuses on a 75-year-old female patient with a documented history of rheumatoid arthritis, who had been undergoing treatment with Leflunomide. The patient presented with bilateral CME and reduced visual acuity (VA). Comprehensive ophthalmic evaluations, including VA tests, fundus examination, and spectral domain optical coherence tomography (SD-OCT, Spectralis®, Heidelberg Engineering), were conducted to assess the extent of the condition and monitor changes over time.
Case Report
A 75-year-old female with underlying dyslipidemia and rheumatoid arthritis presented to the emergency department with a history of CME and reduced VA in both eyes (OU) for several months. She had undergone cataract surgery 20 years earlier in a different hospital and was currently using topical nepafenac, dorzolamide, and dexamethasone prescribed abroad. Initial VA in the right eye (OD) was 20/50 and in the left eye (OS) was 20/40. Fundus examination was notable for macular edema in OU. OCT OU revealed subretinal foveal fluid and intraretinal cysts (Figure 1).
Figure 1.Optical coherence tomography of both eyes revealing subretinal foveal fluid and intraretinal cysts at the patient's initial presentation to our clinic.
Despite ongoing treatment with topical non-steroidal anti-inflammatory drugs, a carbonic anhydrase inhibitor, and corticosteroids, her VA initially improved, but CME continuously recurred upon discontinuation of the therapy. The patient experienced recurrent CME over the course of one year (Figure 2).
Figure 2.Visual acuity (logMAR) measurements before and after discontinuation of Leflunomide.
As expected, the central foveal thickness (CFT) measured by SD-OCT exhibited the same pattern of progression over time as the VA, with periods of improvement and partial or total resolution of the CME, followed by relapses of edema when the topical drugs were tapered (Figure 3).
Figure 3.Central foveal thickness measurements before and after discontinuation of Leflunomide.
Several differential diagnoses were considered. Diabetic macular edema (DME) was ruled out as the patient had no history of diabetes mellitus, which is a primary risk factor for DME. Age-related macular degeneration was considered but discounted due to the absence of characteristic drusen or pigmentary changes on fundus examination and OCT. Uveitis-related macular edema was another potential diagnosis; however, there were no signs of active intraocular inflammation, such as vitritis or anterior chamber cells. Idiopathic central serous chorioretinopathy (CSC) was considered but ruled out based on fundoscopy and OCT findings, as well as the patient's history, epidemiology, and risk factors.
Notably, the patient had been undergoing Leflunomide therapy for the entire duration of CME remission and relapse, as indicated by the fluctuations in CFT and VA (Figure 2 and Figure 3). Drug-induced CME from other medications was considered, but the temporal association with Leflunomide use and the absence of other known offending drugs supported Leflunomide as the likely cause. Given the history of Leflunomide use and the clinical findings, a multidisciplinary approach was adopted. The Rheumatology department was consulted to discuss the potential link between Leflunomide and CME. Based on their input and a comprehensive literature review, and considering the findings of a previously reported case of bilateral Leflunomide-induced CME, it was decided to empirically discontinue the drug. 3 The resolution of CME upon discontinuation of Leflunomide further substantiated this diagnosis.
The patient was closely monitored every three months during the first year following the discontinuation of Leflunomide, and then every six months thereafter. Follow-up evaluations included repeated VA tests, fundus examinations, and SD-OCT imaging to assess the resolution of CME and any improvements in visual function. After two years of discontinuing Leflunomide, the CME resolved without recurrence and without the need for any topical treatment. At her final visit, VA was OD 20/25 and OS 20/25. OCT OU revealed resolution of the CME with a dry fovea (Figure 4).
Figure 4.Optical coherence tomography of both eyes revealing the sustained resolution of the cystoid macular edema after Leflunomide discontinuation.
Although rheumatoid arthritis is known to cause scleritis and vitritis, the timing of the symptoms and their resolution after discontinuing Leflunomide strongly suggest that the drug was the direct cause of the bilateral CME.
Conclusion
This case underscores Leflunomide as a potential, though rare, cause of CME. It emphasizes the importance of considering systemic medications as a causative factor in CME diagnosis. Timely recognition and discontinuation of Leflunomide in such cases may lead to the resolution of CME and prevent further visual impairment. Further studies are needed to elucidate the underlying mechanisms of this rare side effect and to comprehensively report this potential adverse effect.
References
- 1.Gass J D, Norton E W. (1969) Follow-up study of cystoid macular edema following cataract extraction.Trans Am Acad Ophthalmol Otolaryngol. 73, 665-682.
- 2.Scholl S, Kirchhof J, Augustin A J.Pathophysiology of macular edema. , Ophthalmologica 2010, 8-15.
